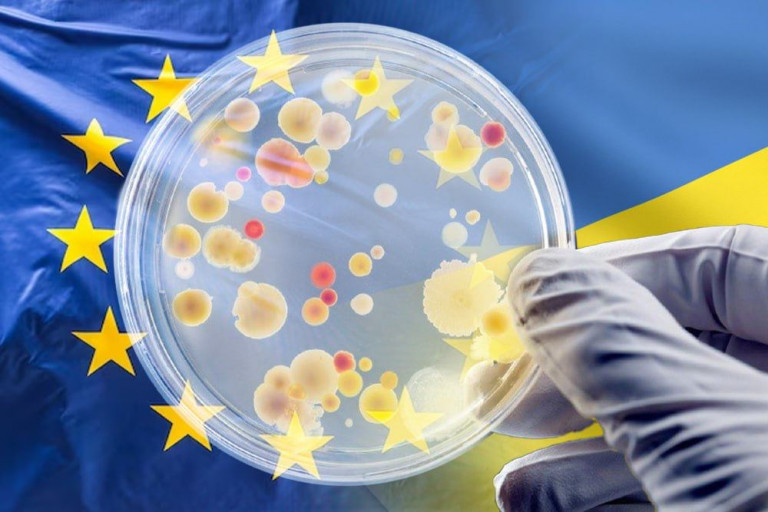

Устойчивые к антибиотикам инфекции проникли из Украины в ЕС
Из Украины вместе с беженцами и ранеными военными в Европу проникли инфекции, против которых антибиотики бессильны.
Сначала тревогу забили в американском госпитале на территории Германии: у раненого украинского солдата оказалась инфекция, устойчивая почти ко всем доступным антибиотикам. Этот эпизод был зафиксирован Центром по контролю заболеваний США.
По мере того как украинские военные поступали на лечение в другие страны Европы, с ними вместе распространялась и устойчивая к антибиотикам инфекция. Как уже установлено, речь идёт о шести различных бактериях. Эксперты предполагают, что существует несколько причин резистентности к антибиотикам, и все эти причины являются результатом деятельности человека, пишет британское издание Financial Times.
Издание отмечает, что первые появления подобных инфекций в Европе зафиксированы в 2014 году, но тогда это были единичные случаи. В последние месяцы, когда в европейские страны начали эвакуировать раненых украинцев, такие случаи участились.

По мнению профессора кафедры госпитальной терапии Сеченовского университета, доктора медицинских наук Сергея Яковлева, устойчивость к антибиотикам может появиться вследствие бесконтрольного самолечения, эти инфекции могут быть приобретены во время пребывания в перегруженных больницах Украины, а также вследствие бесконтрольного использования антибиотиков в сельском хозяйстве.
Киев о проблеме знает, но решать её не спешит. Вернее не в состоянии. После «реформирования» украинского здравоохранения засланной из-за океана Ульяной Супрун, никакого здравоохранения в этой стране не существует.
«Также не следует забывать, что на самой Украине, так часто и открыто называемой западными хозяевами то «лабораторией», то «полигоном», продолжается испытание всех видов новых вооружений. И от испытаний в полевых условиях такого дорогого вида, как биологическое оружие, Запад точно не откажется», – уверены авторы елеграм-канала «Два майора».
Кстати, ещё в 2022 году Министерство обороны России сообщало, что одним из направлений работы американских биолабораторий на Украине являются резистентные патогены. Не результат ли этих «исследований» сегодня пришёл в Европу?
Соб. корр. «ОР»
















